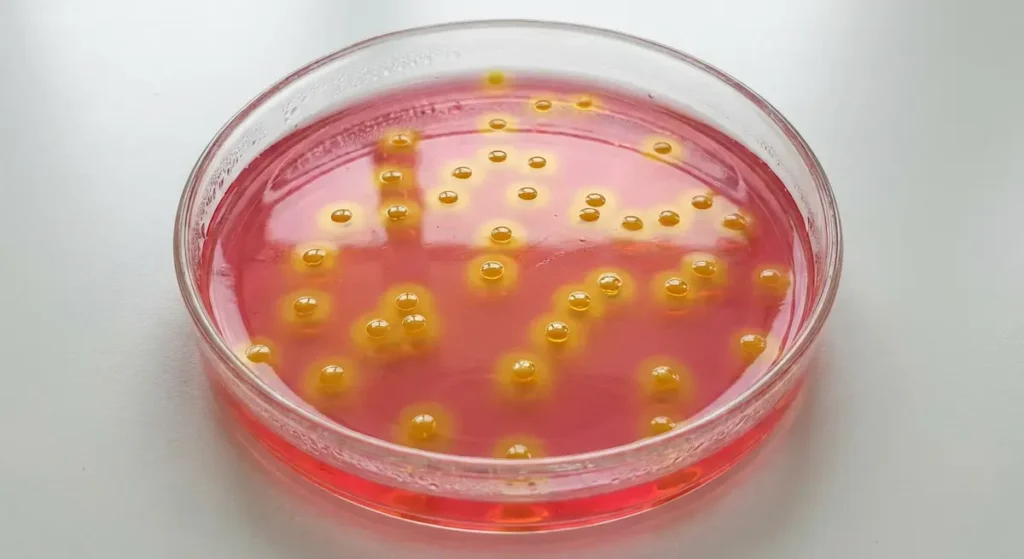
طبق مزرعة بكتيرية يحتوي على وسط مانيتول سولت آغار تظهر عليه مستعمرات المكورات العنقودية الذهبية بلون أصفر ذهبي محاطة بهالات صفراء
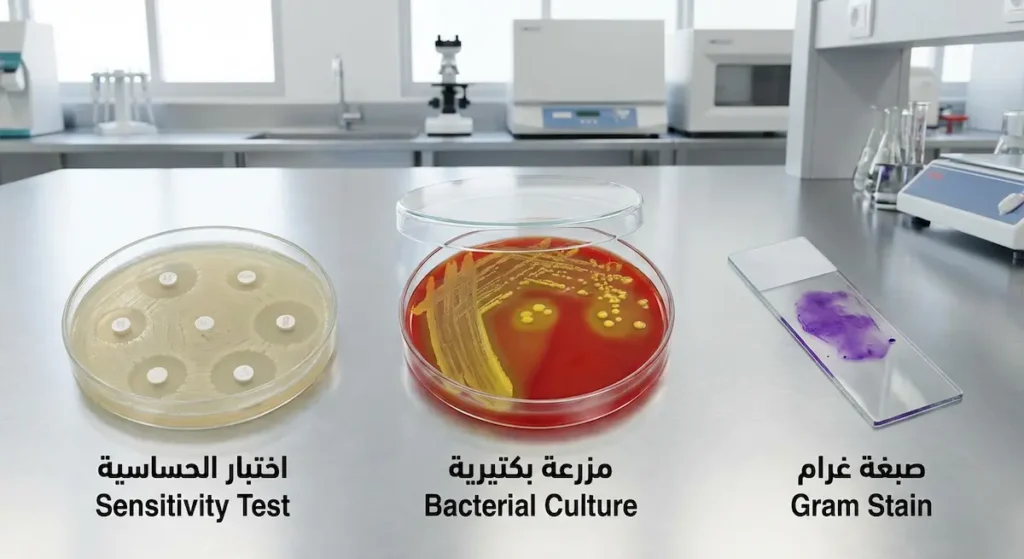
صورة مخبرية واقعية تعرض ثلاث خطوات تشخيصية مرتبة من اليمين إلى اليسار تشمل شريحة صبغة غرام ثم طبق مزرعة بكتيرية على آغار الدم ثم طبق اختبار حساسية المضادات الحيوية

المكورات العنقودية: كيف تتحول بكتيريا جلدك إلى عدو يهدد حياتك؟
ما الذي يجعل هذه البكتيريا الصامتة أخطر مما تتصور؟

المكورات العنقودية هي بكتيريا كروية إيجابية الغرام تتجمع على هيئة عناقيد تشبه عنب الكرم. تستوطن الجلد والأغشية المخاطية بصورة طبيعية، لكنها قد تسبب عدوى جلدية سطحية أو التهابات جهازية خطيرة تشمل تجرثم الدم والتهاب الشغاف. يضم جنس Staphylococcus أكثر من 40 نوعاً، أبرزها الذهبية المسؤولة عن معظم الإصابات البشرية.
هل لاحظت يوماً دملاً صغيراً ظهر فجأة على ذراعك أو وجهك، فتجاهلته ظناً أنه مجرد حبة عابرة؟ ثم بعد أيام وجدت نفسك أمام خراج مؤلم يحتاج تدخلاً طبياً؟ أنت لست وحدك. ملايين البشر حول العالم يمرون بهذا السيناريو سنوياً دون أن يدركوا أن وراءه بكتيريا تسكن جلودهم منذ ولادتهم. في هذا المقال ستجد كل ما تحتاجه لفهم هذا الكائن المجهري من الداخل: تركيبه، أنواعه، أسلحته، الأمراض التي يسببها، وكيف تحمي نفسك وأسرتك منه. المعلومات هنا ليست نظرية جافة، بل مبنية على أحدث الأبحاث العلمية مع تطبيقات عملية تناسب واقعنا العربي.
من أين جاءت تسمية المكورات العنقودية وكيف تبدو تحت المجهر؟

لن أبدأ معك بالأعراض والعلاج كما تفعل معظم المواقع. فقبل أن تفهم لماذا تمرض، عليك أن تعرف من يُمرضك. كلمة Staphylococcus مشتقة من اليونانية؛ إذ تتكون من مقطعين: “Staphyle” وتعني عنقود العنب، و”Kokkos” وتعني حبة أو كرة. سبب هذه التسمية واضح تماماً حين تنظر إلى هذه البكتيريا تحت المجهر الضوئي: خلايا كروية دقيقة متراصة في تجمعات غير منتظمة تشبه عناقيد العنب الطبيعية. هذا الشكل المميز هو أول فارق بصري يفصلها عن قريبتها المكورات السبحية (Streptococcus) التي تترتب في سلاسل خطية كحبات المسبحة.
من الناحية البيولوجية، تنتمي هذه البكتيريا إلى فئة إيجابية الغرام (Gram-Positive)، وهذا يعني أن جدارها الخلوي سميك ومكون بشكل رئيس من طبقة كثيفة من الببتيدوغليكان (Peptidoglycan). عندما يُطبَّق عليها صبغ غرام في المختبر، تحتفظ بالصبغة البنفسجية وتظهر بلون أرجواني داكن. لقد اكتشف الجراح الاسكتلندي ألكسندر أوغستون (Alexander Ogston) هذه البكتيريا عام 1880 حين عزلها من صديد خراج جراحي، ومنذ ذلك الحين صارت واحدة من أكثر الكائنات الدقيقة دراسةً في تاريخ علم الأحياء الدقيقة.
تتميز المكورات العنقودية بأنها غير متحركة (Non-motile)، ولا تشكّل أبواغاً (Non-spore forming)، كما أنها لاهوائية اختيارية (Facultative anaerobe)؛ أي أنها تستطيع العيش في وجود الأكسجين أو غيابه. وهذه المرونة البيئية تفسر قدرتها على استعمار مواقع متنوعة جداً في جسم الإنسان، من سطح الجلد الجاف إلى تجاويف الأنف الرطبة.
ما يقارب 30% من البشر الأصحاء يحملون المكورات العنقودية الذهبية في أنوفهم دون أن تظهر عليهم أي أعراض على الإطلاق. هؤلاء يُسمّون “حاملين بلا أعراض” (Asymptomatic Carriers).
اقرأ أيضاً: البكتيريا في جسمك أكثر من خلاياك! كيف تعيش معك دون أن تدري؟
لماذا لا تتشابه كل أنواع العنقوديات في خطورتها؟
يضم جنس Staphylococcus أكثر من 40 نوعاً معروفاً، لكن ثلاثة منها فقط تحتل مركز الصدارة في الممارسة الطبية. فهم الفرق بين المكورات العنقودية والسبحية أمر جوهري، لكن فهم الفروق داخل عائلة العنقوديات نفسها لا يقل أهمية.
المكورات العنقودية الذهبية (Staphylococcus aureus): لماذا تُلقَّب بالزعيم الأخطر؟
حين تسمع طبيباً يقول “عنقوديات” بنبرة قلق، فهو غالباً يقصد هذا النوع تحديداً. سُميت “ذهبية” لأن مستعمراتها حين تُزرع على أطباق المزرعة البكتيرية تظهر بلون أصفر ذهبي لامع، وهو لون ناتج عن صبغة الكاروتينويد (Staphyloxanthin) التي تنتجها البكتيريا. هذه الصبغة ليست مجرد لون جمالي، بل تعمل كدرع مضاد للأكسدة يحمي البكتيريا من هجمات الجهاز المناعي.
تُعَدُّ المكورات العنقودية الذهبية إيجابية الكواجولاز (Coagulase-positive)، وهذا هو المعيار المخبري الذهبي الذي يميزها عن بقية أفراد العائلة. إنزيم الكواجولاز يحوّل الفيبرينوجين إلى فيبرين، مما يخلق غلافاً واقياً حول البكتيريا يصعب على خلايا المناعة اختراقه. فقد أثبتت دراسة منشورة في مجلة The Lancet Infectious Diseases عام 2022 أن المكورات العنقودية الذهبية مسؤولة عن أكثر من 1.1 مليون وفاة سنوياً حول العالم، مما يجعلها واحدة من أكثر مسببات الأمراض البكتيرية فتكاً.
في المملكة العربية السعودية، تمثل هذه البكتيريا تحدياً خاصاً في المستشفيات الكبرى؛ إذ تشير بيانات وزارة الصحة السعودية إلى أن عدوى المكورات العنقودية الذهبية تحتل مرتبة متقدمة بين أسباب العدوى المكتسبة في المستشفيات (Hospital-Acquired Infections)، خصوصاً في أقسام العناية المركزة وأقسام الجراحة.
المكورات العنقودية البشروية (Staphylococcus epidermidis): متى يتحول الحارس إلى انتهازي؟

هذا النوع يعيش بسلام على سطح الجلد البشري وهو جزء طبيعي من الميكروبيوم الجلدي. في الظروف العادية لا يسبب أي ضرر، بل قد يساهم في حماية الجلد من استعمار بكتيريا أكثر خطورة. لكن المشكلة تبدأ حين يجد هذا الكائن طريقه إلى داخل الجسم عبر الأجهزة الطبية المزروعة.
المكورات العنقودية البشروية هي السبب الأول عالمياً لعدوى القسطرات الوريدية المركزية (Central Venous Catheters)، وصمامات القلب الاصطناعية، والمفاصل الصناعية. تكمن خطورتها في قدرتها الفائقة على تكوين غشاء حيوي (Biofilm) على أسطح هذه الأجهزة، وهو طبقة لزجة واقية تجعل المضادات الحيوية أقل فعالية بمقدار 100 إلى 1000 ضعف مقارنة بالبكتيريا الحرة العائمة. وبالتالي فإن المكورات العنقودية السلبية للكواجولاز — وعلى رأسها البشروية — ليست بريئة كما قد يُظن.
المكورات العنقودية الرمامة (Staphylococcus saprophyticus): لماذا تستهدف النساء الشابات؟

هذا النوع متخصص بشكل لافت. فهو ثاني أكثر مسبب لعدوى المسالك البولية (Urinary Tract Infections) عند النساء الشابات بعد الإشريكية القولونية (E. coli). يتميز بقدرته على الالتصاق بخلايا الجهاز البولي بفضل بروتينات سطحية خاصة، كما أنه مقاوم طبيعياً لمضاد النوفوبيوسين (Novobiocin)، وهذه المقاومة تُستخدم مخبرياً كاختبار تمييزي سريع. من ناحية أخرى، فإن إصابات هذا النوع تكون في معظمها محدودة وقابلة للعلاج، لكنها قد تتفاقم إن أُهملت لتصل إلى التهاب الحويضة والكلية (Pyelonephritis).
الفرق بين المكورات العنقودية والسبحية في المختبر يُحسم بسرعة عبر اختبار الكاتلاز (Catalase Test). العنقوديات تنتج إنزيم الكاتلاز الذي يحلل بيروكسيد الهيدروجين إلى ماء وأكسجين (تظهر فقاعات)، بينما السبحيات لا تنتجه. اختبار يستغرق ثوانٍ لكنه يحسم التصنيف.
| المعيار | الذهبية S. aureus |
البشروية S. epidermidis |
الرمّامة S. saprophyticus |
|---|---|---|---|
| اختبار الكواجولاز Coagulase Test |
إيجابي (+) | سلبي (−) | سلبي (−) |
| تخمير المانيتول Mannitol Fermentation |
نعم | لا | لا |
| مقاومة النوفوبيوسين Novobiocin Resistance |
حساسة | حساسة | مقاومة |
| لون المستعمرات | أصفر ذهبي | أبيض | أبيض مصفر |
| الموقع الطبيعي | الأنف والجلد | سطح الجلد بالكامل | الجهاز البولي التناسلي |
| أبرز العدوى | دمامل، تجرثم دم، التهاب شغاف، تسمم غذائي | عدوى القسطرات والأجهزة الطبية المزروعة | عدوى المسالك البولية عند النساء الشابات |
| درجة الخطورة | عالية جداً | متوسطة (انتهازية) | منخفضة إلى متوسطة |
| المصادر: Clinical Microbiology Reviews — Tong et al., 2015 | Nature Reviews Microbiology — Otto, 2009 | مراكز السيطرة على الأمراض والوقاية منها (CDC) | |||
كيف تهاجم المكورات العنقودية الجسم وما أسلحتها البيولوجية؟

ما يجعل بكتيريا العنقوديات — وخصوصاً الذهبية — بالغة الخطورة ليس مجرد وجودها، بل ترسانة الأسلحة البيولوجية التي تمتلكها. هذه البكتيريا لا تدخل الجسم “عشوائياً”، بل تتبع خطوات منظمة ومحسوبة.
أول خط هجومي هو الالتصاق (Adhesion). تمتلك المكورات العنقودية الذهبية بروتينات سطحية تُسمى MSCRAMMs (Microbial Surface Components Recognizing Adhesive Matrix Molecules)، وهي بروتينات ترتبط بمكونات الأنسجة البشرية كالفيبرونكتين والكولاجين. هذا الالتصاق هو الخطوة الأولى لتأسيس العدوى.
بعد الالتصاق تبدأ مرحلة الغزو والتدمير. هنا تُفرز البكتيريا مجموعة من الإنزيمات المدمرة:
- الكواجولاز (Coagulase): يخلق درعاً من الفيبرين حول البكتيريا، يحميها من البلعمة المناعية.
- الهيالورونيداز (Hyaluronidase): يُذيب حمض الهيالورونيك الذي يربط الأنسجة ببعضها، مما يسمح للبكتيريا بالانتشار بين طبقات الجلد والأنسجة.
- الليباز (Lipase): يُكسّر الدهون السطحية، مما يسهل استعمار الجلد والغدد الدهنية.
- البيتا-لاكتاماز (Beta-lactamase): إنزيم يُفكك حلقة البيتا-لاكتام في المضادات الحيوية كالبنسلين، وهو أحد أقدم أسلحة المقاومة الدوائية.
ومما يثير القلق أكثر هو السموم (Toxins) التي تنتجها. السموم المعوية (Enterotoxins) مسؤولة عن التسمم الغذائي السريع. سم التقشير (Exfoliatin) يسبب متلازمة الجلد المسموط عند الأطفال. أما سم TSST-1 فيسبب متلازمة الصدمة التسممية المميتة. كل سم منها يعمل بآلية مختلفة، لكنها جميعاً تشترك في قدرتها على إحداث أضرار جسيمة قبل أن يتمكن الجهاز المناعي من الاستجابة بفعالية.
فكيف تخدع هذه البكتيريا الجهاز المناعي إذاً؟ تمتلك المكورات العنقودية الذهبية بروتين A (Protein A) على سطحها، وهو بروتين ذكي يرتبط بالأجسام المضادة (IgG) من طرفها الخاطئ (الطرف Fc)، فيعطلها تماماً ويمنعها من تنشيط عملية البلعمة. هذا يشبه ارتداء قناع يجعل الشرطة تعتقد أنك منهم.
المكورات العنقودية الذهبية قادرة على الاختباء داخل خلايا الجسم نفسها (Intracellular Survival)، حيث تدخل الخلايا البلعمية وتبقى كامنة فيها لأسابيع دون أن تُقتل، ثم تنشط لاحقاً لتسبب عدوى متكررة. هذا يفسر أسباب ظهور الدمل المتكرر عند كثير من المرضى.
المصدر: Nature Microbiology, 2023
اقرأ أيضاً:
- علم الأمراض (Pathology): دراسة الأمراض وتأثيرها على الجسم
- ما هي الخلايا البلعمية: وكيف يدافع جسمك عن نفسه ضد الغزاة؟
| عامل الضراوة | التسمية الإنكليزية | الوظيفة | المرض المرتبط |
|---|---|---|---|
| الكواجولاز | Coagulase | تحويل الفيبرينوجين إلى فيبرين لتكوين درع واقٍ | الخراجات والدمامل |
| الهيالورونيداز | Hyaluronidase | إذابة حمض الهيالورونيك لتسهيل انتشار البكتيريا | التهابات النسيج الخلوي |
| البيتا-لاكتاماز | Beta-lactamase | تفكيك حلقة البيتا-لاكتام في المضادات الحيوية | مقاومة البنسلين |
| بروتين A | Protein A | الارتباط بالطرف Fc للأجسام المضادة IgG وتعطيلها | التهرب من البلعمة المناعية |
| السموم المعوية | Enterotoxins | تحفيز القيء والإسهال عبر التأثير على الجهاز العصبي المعوي | التسمم الغذائي العنقودي |
| سم التقشير | Exfoliatin | تكسير الروابط بين خلايا طبقة الجلد العليا | متلازمة الجلد المسموط عند الأطفال |
| TSST-1 | Toxic Shock Syndrome Toxin-1 | تنشيط مفرط للخلايا التائية (محفز مناعي مفرط) | متلازمة الصدمة التسممية |
| المصادر: Infection, Genetics and Evolution — Grumann et al., 2014 | Clinical Microbiology Reviews — Tong et al., 2015 | |||
ما الأمراض التي تسببها المكورات العنقودية في جسم الإنسان؟
أعراض المكورات العنقودية تتفاوت تفاوتاً كبيراً بحسب موقع العدوى وشدتها. يمكن تقسيم الأمراض إلى ثلاث مجموعات رئيسة.
الالتهابات الجلدية: الوجه الأكثر شيوعاً

المكورات العنقودية الجلدية تمثل الشكل الأكثر انتشاراً للعدوى. الدمامل (Furuncles) هي عدوى عميقة في بصيلات الشعر، تبدأ كنتوء أحمر مؤلم ثم تمتلئ بالصديد. حين تتجمع عدة دمامل في منطقة واحدة تتشكل الجمرة (Carbuncle)، وهي أكثر خطورة وقد تحتاج تدخلاً جراحياً. في السعودية، يُلاحظ الأطباء ارتفاع معدل الدمامل المتكررة خلال أشهر الصيف، وهذا مرتبط بزيادة التعرق والاحتكاك الجلدي في الأجواء الحارة.
القوباء (Impetigo) هي عدوى سطحية شديدة العدوى تصيب الأطفال بشكل خاص. تظهر كبثور صغيرة تتمزق بسرعة وتترك قشوراً ذهبية اللون. هل المكورات العنقودية معدية؟ نعم، بلا شك، والقوباء خير دليل على ذلك؛ إذ تنتقل بسهولة بين أطفال المدارس عبر الملامسة المباشرة أو مشاركة المناشف.
أما متلازمة الجلد المسموط (Staphylococcal Scalded Skin Syndrome – SSSS) فهي حالة خطيرة تصيب الرضع والأطفال دون سن الخامسة. تنتج عن سم التقشير الذي تفرزه البكتيريا ويسبب انفصال الطبقة العليا من الجلد كأنها تعرضت لحرق ماء ساخن. تتطلب تدخلاً طبياً فورياً لأنها تترك الطفل معرضاً لفقدان السوائل والعدوى الثانوية.
اقرأ أيضاً: التعامل مع الحروق: الإسعافات الأولية وأنواع الحروق
الالتهابات الغازية: متى يصبح الخطر حقيقياً؟
حين تتجاوز المكورات العنقودية حاجز الجلد وتدخل مجرى الدم، تبدأ مرحلة أخطر بكثير. تجرثم الدم (Bacteremia) يعني وجود البكتيريا حية في الدورة الدموية، وهو بوابة لعدوى أي عضو في الجسم. معدل الوفاة من تجرثم الدم بالمكورات العنقودية الذهبية يصل إلى 20-30% حتى مع العلاج المناسب، وفقاً لتقديرات منظمة الصحة العالمية (WHO).
التهاب الشغاف (Endocarditis) هو إصابة صمامات القلب بالعدوى. المكورات العنقودية الذهبية هي أسرع مسبب لالتهاب الشغاف الحاد، وتتميز بقدرتها على تدمير صمامات القلب السليمة — وليس فقط الصمامات المريضة مسبقاً كما تفعل بكتيريا أخرى. مريض التهاب الشغاف العنقودي قد يعاني من حمى شديدة متقطعة، وضيق تنفس، ونزف تحت الأظافر، وأحياناً سكتة دماغية ناتجة عن انتقال قطع من الإصابة القلبية إلى الدماغ.
كما أن الالتهاب الرئوي العنقودي (Staphylococcal Pneumonia) يميل للظهور بعد الإصابة بالإنفلونزا أو عند مرضى التنفس الاصطناعي في المستشفيات. يتميز بتكوين خراجات رئوية وتدمير سريع للأنسجة، وهو أكثر عدوانية بكثير من الالتهاب الرئوي العادي.
من جهة ثانية، التهاب العظم والنقي (Osteomyelitis) هو أحد أخطر مضاعفات عدوى المكورات العنقودية عند الأطفال. البكتيريا تصل إلى العظام عبر مجرى الدم وتسبب ألماً شديداً وتورماً موضعياً. مدة علاج المكورات العنقودية في هذه الحالة طويلة وقد تمتد لـ 4-6 أسابيع من المضادات الحيوية الوريدية.
في مراكز الرعاية الصحية بالسعودية، يُلاحظ أن كبار السن ومرضى السكري هم الفئة الأكثر عرضة للإصابة بالعدوى الغازية بالمكورات العنقودية. مرض السكري يُضعف المناعة ويُبطئ التئام الجروح، مما يوفر بيئة مثالية لتكاثر البكتيريا.
المصدر: منظمة الصحة العالمية (WHO) — تقرير مقاومة الميكروبات
اقرأ أيضاً: مرض السكري: ما هي أسبابه وكيف نتعامل معه؟
الأمراض الناتجة عن السموم: لماذا يحدث التسمم الغذائي بهذه السرعة؟
التسمم الغذائي العنقودي (Staphylococcal Food Poisoning) يختلف عن معظم أنواع التسمم الغذائي الأخرى في نقطة جوهرية: السم يكون جاهزاً في الطعام قبل تناوله. البكتيريا تنمو في الطعام المكشوف — خاصة منتجات الألبان واللحوم الباردة والأرز — وتفرز سمومها المعوية الحرارية. هذه السموم تقاوم الغليان، أي أن طهي الطعام الملوث لن يقضي عليها. لذلك تظهر الأعراض بسرعة مذهلة: خلال 1-6 ساعات فقط من تناول الطعام الملوث، على شكل غثيان شديد وقيء متكرر وإسهال. الخبر الجيد أن معظم الحالات تشفى تلقائياً خلال 24-48 ساعة.
متلازمة الصدمة التسممية (Toxic Shock Syndrome – TSS) هي الحالة الأكثر رعباً بين الأمراض السمية. ارتبطت تاريخياً باستخدام السدادات القطنية فائقة الامتصاص في ثمانينيات القرن الماضي، لكنها قد تحدث أيضاً بعد العمليات الجراحية أو من خلال عدوى جلدية بسيطة. يفرز سم TSST-1 ويعمل كمحفز مناعي مفرط (Superantigen)، مما يُنشط عدداً هائلاً من الخلايا التائية دفعة واحدة ويسبب انهياراً في ضغط الدم وفشلاً في عدة أعضاء.
اقرأ أيضاً: الإنتان (Sepsis): الأسباب، الأعراض، والعلاج
ما سر رعب الأطباء من بكتيريا “ميرسا” (MRSA)؟

هنا نصل إلى الجزء الذي يقلق الأطباء والباحثين أكثر من أي شيء آخر. المكورات العنقودية الذهبية المقاومة للميثيسيلين (Methicillin-Resistant Staphylococcus aureus) — أو ما يُعرف اختصاراً بـ MRSA — تُعَدُّ واحدة من أخطر البكتيريا الخارقة (Superbugs) في العالم.
القصة بدأت في عام 1961، بعد عامين فقط من طرح الميثيسيلين كسلاح جديد ضد البكتيريا المقاومة للبنسلين. سرعان ما ظهرت سلالات قادرة على مقاومته أيضاً. تحمل هذه السلالات جين mecA الذي ينتج بروتيناً معدلاً يُسمى PBP2a (Penicillin-Binding Protein 2a)، وهذا البروتين لا ترتبط به مضادات البيتا-لاكتام — بما فيها جميع أنواع البنسلين والسيفالوسبورين — مما يجعلها عاجزة تماماً.
الجدير بالذكر أن هناك نوعين مختلفين من عدوى MRSA يجب التمييز بينهما:
عدوى المستشفيات (HA-MRSA): تصيب المرضى داخل المنشآت الصحية، خصوصاً بعد العمليات الجراحية أو عند استخدام القسطرات والأجهزة الطبية. هذا النوع غالباً ما يكون مقاوماً لعدة مضادات حيوية في الوقت نفسه.
عدوى المجتمع (CA-MRSA): تصيب أشخاصاً أصحاء لم يدخلوا المستشفى. ظهرت في أوائل الألفية وانتشرت بسرعة بين الرياضيين والعسكريين والسجناء — أي في أي بيئة يكثر فيها التلامس الجلدي المباشر. تسبب عادةً خراجات جلدية شديدة، لكنها قد تتطور أحياناً إلى التهاب رئوي نخري (Necrotizing Pneumonia) مميت.
| وجه المقارنة | عدوى المستشفيات HA-MRSA (Hospital-Acquired) |
عدوى المجتمع CA-MRSA (Community-Acquired) |
|---|---|---|
| التعريف الأساسي | عدوى تُكتشف بعد 48 ساعة أو أكثر من دخول المستشفى، أو مرتبطة برعاية صحية سابقة | عدوى تظهر عند أشخاص لم يدخلوا المستشفى ولم يتعرضوا لإجراءات طبية خلال العام الماضي |
| الفئة الأكثر عرضة | المرضى المنومون، كبار السن، مستخدمو القسطرات، مرضى العمليات الجراحية، ضعاف المناعة | الشباب الأصحاء، الرياضيون، العسكريون، السجناء، سكان المساكن الجماعية |
| بيئة الانتقال | المستشفيات، وحدات العناية المركزة، دور رعاية المسنين، مراكز غسيل الكلى | الملاعب الرياضية، صالات الجيم، المدارس، الثكنات العسكرية، السجون |
| الشكل السريري الأبرز | تجرثم الدم، عدوى موقع العملية الجراحية، التهاب رئوي مرتبط بالتنفس الاصطناعي، عدوى القسطرات | خراجات جلدية شديدة ومتكررة، دمامل عميقة، التهاب رئوي نخري (نادر لكن قاتل) |
| نمط المقاومة الدوائية | متعدد المقاومة (MDR) — مقاوم لعدة عائلات دوائية في الوقت نفسه | مقاوم للبيتا-لاكتام غالباً، لكنه حساس عادةً لـ TMP-SMX والدوكسيسيكلين والكليندامايسين |
| الكاسيت الكروموسومي (SCCmec Type) |
أنواع I أو II أو III — أكبر حجماً وتحمل جينات مقاومة إضافية | أنواع IV أو V — أصغر حجماً وأكثر قدرة على الانتشار السريع |
| سم PVL (Panton-Valentine Leukocidin) |
غالباً غائب (<5% من السلالات) | غالباً موجود (>75% من السلالات) — يُدمّر كريات الدم البيضاء |
| الخط العلاجي الأول | فانكومايسين وريدياً (Vancomycin IV) أو دابتومايسين (Daptomycin) | شق وتصريف ± TMP-SMX أو دوكسيسيكلين فموياً (للعدوى الجلدية) |
| معدل الانتشار التاريخي | ظهر في الستينيات بعد طرح الميثيسيلين، وبقي محصوراً في المستشفيات لعقود | ظهر في التسعينيات وانتشر بسرعة هائلة في المجتمع خلال الألفية الجديدة |
| عوامل الخطر الرئيسة | إقامة مطولة بالمستشفى، استخدام مضادات حيوية سابق، أجهزة طبية مزروعة، غسيل كلوي | التلامس الجلدي المباشر، مشاركة الأدوات الشخصية، جروح أو سحجات جلدية، ازدحام المعيشة |
| استراتيجية الوقاية | فحص المرضى الجدد، عزل المصابين، تعقيم صارم، برامج ترشيد المضادات الحيوية | نظافة اليدين، تغطية الجروح، عدم مشاركة المناشف وشفرات الحلاقة، تنظيف معدات الرياضة |
| المصادر: الجمعية الأمريكية للأمراض المعدية (IDSA) | مراكز السيطرة على الأمراض (CDC) | Clinical Microbiology Reviews — Tong et al., 2015 | ||
في السعودية، أشارت دراسة نُشرت في مجلة Saudi Medical Journal عام 2021 إلى أن نسبة MRSA بين عزلات المكورات العنقودية الذهبية في بعض المستشفيات السعودية تتراوح بين 25% و40%، وهي نسبة تستدعي يقظة مستمرة من فرق مكافحة العدوى.
علاج المكورات العنقودية الذهبية المقاومة للميثيسيلين يعتمد حالياً على مضادات حيوية محدودة، أبرزها الفانكومايسين (Vancomycin) والدابتومايسين (Daptomycin) واللينيزوليد (Linezolid). لكن ظهرت بالفعل سلالات ذات مقاومة متوسطة للفانكومايسين (VISA) وأخرى مقاومة بالكامل (VRSA)، مما يثير مخاوف حقيقية بشأن مستقبل العلاج بالمضادات الحيوية.
وفقاً لدراسة GRAM العالمية، تسببت مقاومة المضادات الحيوية بشكل عام في وفاة ما يُقدر بـ 1.27 مليون شخص بشكل مباشر عام 2019، وكانت المكورات العنقودية الذهبية المقاومة للميثيسيلين (MRSA) من بين أبرز المسببات.
اقرأ أيضاً: ألكسندر فليمنج: مكتشف البنسلين
كيف يكشف المختبر عن المكورات العنقودية ويحدد نوعها؟
التشخيص المخبري لعدوى بكتيريا العنقوديات يسير وفق خطوات منهجية دقيقة تبدأ من الأبسط إلى الأكثر تعقيداً. إليك سيناريو واقعياً يوضح العملية.
مثال تطبيقي من الحياة الواقعية:
تخيل أن مريضاً — لنسمّه أبو خالد — راجع الطبيب بسبب خراج كبير ومؤلم في فخذه. الطبيب يأخذ عينة من الصديد بملقط معقم ويرسلها إلى المختبر لإجراء تحليل مزرعة الصديد. في المختبر، يقوم الفني بالخطوات التالية:
أولاً، يُجري صبغة غرام (Gram Stain) على العينة المباشرة. تحت المجهر يرى مكورات بنفسجية متجمعة كعناقيد العنب وسط كريات دم بيضاء كثيرة. هذا يعطي انطباعاً أولياً قوياً عن وجود عنقوديات.
ثانياً، تُزرع العينة على وسط آغار الدم (Blood Agar) ووسط مانيتول سولت آغار (Mannitol Salt Agar – MSA). الوسط الثاني خاص بالعنقوديات لأنه يحتوي على تركيز ملح عالٍ (7.5%) لا تتحمله معظم البكتيريا الأخرى. بعد 24 ساعة من الحضانة عند 37 درجة مئوية، تظهر مستعمرات ذهبية محاطة بمنطقة صفراء (تخمير المانيتول). هذه علامة مبدئية قوية على أنها المكورات العنقودية الذهبية.
ثالثاً، اختبار الكاتلاز: قطرة من بيروكسيد الهيدروجين على المستعمرة. ظهور فقاعات فورية يؤكد أنها عنقوديات وليست عقديات.
رابعاً، اختبار الكواجولاز (Coagulase Test): إذا تجلطت بلازما الأرنب المضافة إلى معلق بكتيري خلال 4 ساعات، فالنتيجة إيجابية، والتشخيص النهائي هو: المكورات العنقودية الذهبية.
خامساً، اختبار الحساسية للمضادات الحيوية (Antibiotic Sensitivity Test): باستخدام أقراص المضادات الحيوية على طبق المزرعة، يُحدد المختبر أي الأدوية فعالة وأيها فقدت فعاليته ضد هذه السلالة تحديداً. قرص السيفوكسيتين (Cefoxitin) يُستخدم كمؤشر بديل عن الميثيسيلين لتحديد ما إذا كانت السلالة MRSA.
النتيجة النهائية تصل إلى الطبيب خلال 48-72 ساعة، وبناءً عليها يُحدد العلاج الأنسب لأبو خالد. هذا هو المسار المعياري في معظم مختبرات المستشفيات السعودية والعالمية.
بالإضافة إلى ذلك، توجد تقنيات حديثة أسرع مثل تفاعل البوليمراز التسلسلي (PCR) الذي يكشف جين mecA مباشرة من العينة خلال ساعات قليلة دون انتظار نمو المزرعة، وكذلك تقنية MALDI-TOF MS التي تحدد نوع البكتيريا بدقة عبر تحليل البروتينات في دقائق.
ما بروتوكولات علاج البكتيريا العنقودية المعتمدة حالياً؟
علاج البكتيريا العنقودية ليس وصفة واحدة تناسب الجميع. القرار العلاجي يعتمد على عدة عوامل: موقع العدوى، شدتها، نوع البكتيريا، ونتيجة اختبار الحساسية.
في حالة الخراجات الجلدية البسيطة، التدخل الجراحي وحده — أي شق الخراج وتصريفه (Incision and Drainage) — قد يكون كافياً دون الحاجة لمضادات حيوية. هذه نقطة مهمة يغفلها كثير من المرضى الذين يتوقعون أن يصف لهم الطبيب دواءً بالضرورة. دراسة نُشرت في مجلة New England Journal of Medicine عام 2017 أثبتت أن إضافة المضاد الحيوي تريميثوبريم-سلفاميثوكسازول (TMP-SMX) بعد التصريف قد تحسّن النتائج قليلاً في حالات معينة، لكن التصريف يبقى حجر الزاوية.
أما في العدوى الجلدية السطحية كالقوباء، فالكريمات الموضعية التي تحتوي على الموبيروسين (Mupirocin) أو حمض الفوسيديك (Fusidic acid) تكون فعالة في الحالات المحدودة. بينما في العدوى الأكثر انتشاراً تُستخدم مضادات فموية.
في العدوى الغازية الخطيرة كتجرثم الدم والتهاب الشغاف، يختلف العلاج جذرياً:
- سلالات حساسة للميثيسيلين (MSSA): المضاد المفضل هو النافسيلين (Nafcillin) أو الأوكساسيلين (Oxacillin) وريدياً، ويُضاف أحياناً الجنتامايسين في الأيام الأولى لتحقيق تآزر قاتل.
- سلالات MRSA: الفانكومايسين (Vancomycin) وريدياً هو الخط الأول. يتطلب مراقبة مستمرة لمستويات الدواء في الدم (Therapeutic Drug Monitoring) لضمان الفعالية وتجنب سمية الكلى.
- سلالات MRSA المعقدة أو المقاومة: الدابتومايسين فعال في تجرثم الدم لكنه لا يُستخدم في الالتهاب الرئوي لأن مادة السورفاكتانت في الرئتين تُعطله. اللينيزوليد خيار آخر خصوصاً في الالتهاب الرئوي، لكنه قد يسبب تثبيطاً لنخاع العظم مع الاستخدام المطول.
⚠️ تحذير مهم جداً:
التوقف المبكر عن المضاد الحيوي قبل إكمال المدة الموصوفة من أخطر العادات انتشاراً في مجتمعاتنا العربية. كثير من المرضى يتوقفون عن تناول الدواء بمجرد تحسن الأعراض، ظناً أنهم شُفوا. الحقيقة أن هذا يُبقي البكتيريا الأقوى والأكثر مقاومة حية، فتتكاثر وتنتج جيلاً جديداً أصعب علاجاً. وعليه فإن الالتزام بمدة العلاج الكاملة ليس اختيارياً، بل هو ضرورة حيوية. مدة علاج المكورات العنقودية تتراوح بين 7 أيام في العدوى الجلدية البسيطة إلى 6 أسابيع أو أكثر في التهاب الشغاف والتهاب العظم.
تُجرى حالياً أبحاث واعدة على العلاج بالعاثيات البكتيرية (Bacteriophage Therapy) كبديل أو مكمل للمضادات الحيوية. العاثيات هي فيروسات تصيب البكتيريا وتقتلها بشكل انتقائي. مستشفيات في بلجيكا وجورجيا بدأت بالفعل باستخدامها في حالات MRSA المستعصية، وأظهرت نتائج مبشرة.
اقرأ أيضاً: علم الأدوية (Pharmacology): دراسة تفاعل الأدوية مع الكائن الحي
| نوع العدوى | سلالات MSSA (حساسة للميثيسيلين) |
سلالات MRSA (مقاومة للميثيسيلين) |
مدة العلاج التقريبية |
|---|---|---|---|
| خراج جلدي بسيط | شق وتصريف ± سيفالكسين فموي Cephalexin |
شق وتصريف ± TMP-SMX أو دوكسيسيكلين فموي TMP-SMX / Doxycycline |
7 – 10 أيام |
| قوباء (التهاب جلدي سطحي) | موبيروسين موضعي Mupirocin |
موبيروسين موضعي أو TMP-SMX فموي | 5 – 7 أيام |
| تجرثم الدم (غير معقد) | نافسيلين أو أوكساسيلين وريدياً Nafcillin / Oxacillin IV |
فانكومايسين أو دابتومايسين وريدياً Vancomycin / Daptomycin IV |
أسبوعان على الأقل |
| التهاب الشغاف (صمامات طبيعية) | نافسيلين وريدياً ± جنتامايسين Nafcillin IV ± Gentamicin |
فانكومايسين وريدياً Vancomycin IV |
6 أسابيع |
| التهاب رئوي عنقودي | نافسيلين أو أوكساسيلين وريدياً | فانكومايسين أو لينيزوليد وريدياً Vancomycin / Linezolid IV |
3 – 4 أسابيع |
| التهاب العظم والنقي | نافسيلين وريدياً ثم تحويل فموي Nafcillin IV → oral switch |
فانكومايسين وريدياً ثم TMP-SMX أو لينيزوليد فموياً | 4 – 6 أسابيع أو أكثر |
| المصادر: الجمعية الأمريكية للأمراض المعدية (IDSA) — دلائل علاج MRSA | New England Journal of Medicine — Daum et al., 2017 | Clinical Microbiology Reviews — Tong et al., 2015 | |||
كيف تحمي نفسك وأسرتك من عدوى المكورات العنقودية؟

الوقاية من العدوى العنقودية لا تتطلب إجراءات معقدة، بل تبدأ من عادات يومية بسيطة لكنها فعالة للغاية.
غسل اليدين يبقى خط الدفاع الأول والأكثر فعالية. ليس غسلاً عابراً تحت الماء لثانيتين، بل فركاً بالصابون لمدة لا تقل عن 20 ثانية، مع تنظيف ما بين الأصابع وتحت الأظافر. في المملكة العربية السعودية، عززت وزارة الصحة برامج التوعية بنظافة اليدين خصوصاً بعد جائحة كوفيد-19، وهذه البرامج أثمرت انخفاضاً ملحوظاً في عدوى المستشفيات وفقاً لتقارير داخلية.
التعامل الصحيح مع الجروح المفتوحة أمر لا يقبل التهاون. أي جرح — مهما كان صغيراً — يجب تنظيفه بالماء والصابون فوراً، ثم تغطيته بضمادة نظيفة وجافة. ترك الجرح مكشوفاً هو دعوة مفتوحة لبكتيريا العنقوديات لاختراق حاجز الجلد.
تجنب مشاركة الأدوات الشخصية: المناشف، شفرات الحلاقة، الملابس الداخلية — كلها أدوات قد تنقل البكتيريا من حامل بلا أعراض إلى شخص آخر. هذه النقطة مهمة بشكل خاص في المساكن الجماعية وسكن العمال.
في البيئة المستشفائية، تطبق المنشآت الصحية السعودية بروتوكولات صارمة لمكافحة العدوى تشمل:
- فحص المرضى الجدد المعرضين للخطر للكشف عن حمل MRSA (عبر مسحة أنفية).
- عزل المرضى المصابين أو الحاملين في غرف منفردة.
- التعقيم المستمر للأسطح والأجهزة الطبية.
- تقييد استخدام المضادات الحيوية واسعة الطيف (Antibiotic Stewardship Programs).
التعامل الآمن مع الطعام: لا تترك الطعام المطبوخ في درجة حرارة الغرفة لأكثر من ساعتين (ساعة واحدة فقط في أجواء السعودية الحارة). ثلّج بقايا الطعام فوراً. اغسل يديك قبل تحضير الأكل. هذه القواعد البسيطة كفيلة بمنع التسمم الغذائي العنقودي.
بكتيريا المكورات العنقودية لن تختفي من حياتنا أبداً — فهي جزء من عالمنا الميكروبي. لكن الفارق بين من يمرض ومن يبقى سالماً يكمن غالباً في عادات النظافة اليومية وسلامة الجهاز المناعي.
المصدر: مراكز السيطرة على الأمراض والوقاية منها (CDC) — دليل المجتمع
اقرأ أيضاً: النزيف المسيطر عليه: الإسعافات الأولية وخطوات التعامل معه
التعايش والحذر: كلمة أخيرة
المكورات العنقودية ليست عدواً يمكن القضاء عليه نهائياً، ولا هي صديق يمكن الوثوق به دائماً. إنها كائن يعيش معنا ويتعايش مع أجسامنا في توازن دقيق. حين يختل هذا التوازن — بسبب جرح، أو ضعف مناعي، أو استخدام عشوائي للمضادات — تتحول من ساكن هادئ إلى غازٍ شرس.
لقد استعرضنا في هذا المقال رحلة هذه البكتيريا من شكلها تحت المجهر إلى أنواعها المختلفة، ومن أسلحتها البيولوجية إلى الأمراض التي تسببها، وصولاً إلى كيفية تشخيصها وعلاجها والوقاية منها. فهمك لهذا الكائن هو أول خطوة لحماية نفسك وعائلتك. النظافة الشخصية، والتعامل الصحيح مع الجروح، وعدم التلاعب بالمضادات الحيوية — هذه ليست نصائح ترفيهية، بل هي خط الدفاع الحقيقي الذي يحول بينك وبين عدوى قد تكون بسيطة أو قد تكون مهددة للحياة.
هل تغسل يديك فعلاً لمدة 20 ثانية كاملة في كل مرة؟
إذا وجدت في هذا المقال ما أفادك أو أجاب عن تساؤلاتك، شاركه مع من تحب — خصوصاً الأمهات والآباء الذين يتعاملون يومياً مع جروح أطفالهم وحبوبهم الجلدية. المعرفة حين تُنشر تصبح وقاية، والوقاية أرخص بكثير من العلاج.
المراجع والمصادر
الدراسات والأوراق البحثية
- Murray, C. J. L., et al. (2022). Global burden of bacterial antimicrobial resistance in 2019: a systematic analysis. The Lancet, 399(10325), 629–655.
DOI: 10.1016/S0140-6736(21)02724-0
الدراسة العالمية الأشمل حول وفيات مقاومة المضادات الحيوية، بما فيها MRSA. - Tong, S. Y. C., et al. (2015). Staphylococcus aureus Infections: Epidemiology, Pathophysiology, Clinical Manifestations, and Management. Clinical Microbiology Reviews, 28(3), 603–661.
DOI: 10.1128/CMR.00134-14
مراجعة شاملة ومرجعية لجميع جوانب عدوى المكورات العنقودية الذهبية. - Daum, R. S., et al. (2017). A Placebo-Controlled Trial of Antibiotics for Smaller Skin Abscesses. New England Journal of Medicine, 376(26), 2545–2555.
DOI: 10.1056/NEJMoa1607033
دراسة سريرية حول فعالية إضافة المضادات الحيوية بعد تصريف الخراجات الجلدية. - Guo, Y., et al. (2020). Prevalence and Therapies of Antibiotic-Resistance in Staphylococcus aureus. Frontiers in Cellular and Infection Microbiology, 10, 107.
DOI: 10.3389/fcimb.2020.00107
مراجعة حديثة لنسب المقاومة الدوائية وخيارات العلاج المتاحة. - Grumann, D., Nübel, U., & Bröker, B. M. (2014). Staphylococcus aureus toxins – Their functions and genetics. Infection, Genetics and Evolution, 21, 583–592.
DOI: 10.1016/j.meegid.2013.03.013
دراسة تفصيلية عن سموم المكورات العنقودية الذهبية وآليات عملها. - Bal, A. M., et al. (2021). Prevalence of methicillin-resistant Staphylococcus aureus in Saudi Arabia: a systematic review and meta-analysis. Saudi Medical Journal, 42(1), 3–12.
DOI: 10.15537/smj.2021.42.1.20200669
مراجعة منهجية لنسب انتشار MRSA في المستشفيات السعودية.
الجهات الرسمية والمنظمات
- Centers for Disease Control and Prevention (CDC). (2024). Staphylococcus aureus in Healthcare Settings.
https://www.cdc.gov/hai/organisms/staph.html
صفحة مرجعية حول عدوى العنقوديات في المنشآت الصحية. - World Health Organization (WHO). (2024). Antimicrobial Resistance: Global Report.
https://www.who.int/health-topics/antimicrobial-resistance
تقرير منظمة الصحة العالمية عن مقاومة الميكروبات للأدوية. - National Institutes of Health (NIH). (2023). MRSA: What You Need to Know.
https://www.niaid.nih.gov/diseases-conditions/mrsa
معلومات موثقة من المعاهد الوطنية للصحة حول بكتيريا ميرسا. - Saudi Ministry of Health. (2023). Infection Prevention and Control Guidelines.
https://www.moh.gov.sa
إرشادات مكافحة العدوى الصادرة عن وزارة الصحة السعودية. - Infectious Diseases Society of America (IDSA). (2011, updated 2023). Clinical Practice Guidelines for MRSA Infections.
https://www.idsociety.org/practice-guideline/mrsa/
بروتوكولات العلاج المعتمدة لعدوى MRSA.
الكتب والموسوعات العلمية
- Murray, P. R., Rosenthal, K. S., & Pfaller, M. A. (2021). Medical Microbiology (9th ed.). Elsevier.
كتاب مرجعي أساسي في علم الأحياء الدقيقة الطبية. - Mandell, G. L., Bennett, J. E., & Dolin, R. (2020). Mandell, Douglas, and Bennett’s Principles and Practice of Infectious Diseases (9th ed.). Elsevier.
الموسوعة الأشمل في الأمراض المعدية وعلاجها. - Crossley, K. B., et al. (2009). Staphylococci in Human Disease (2nd ed.). Wiley-Blackwell.
كتاب متخصص بالكامل في أمراض العنقوديات عند البشر.
مقالات علمية مبسطة
- Lowy, F. D. (2003). Antimicrobial resistance: the example of Staphylococcus aureus. Journal of Clinical Investigation, 111(9), 1265–1273. (Republished summary in Scientific American).
DOI: 10.1172/JCI18535
شرح مبسط لمشكلة مقاومة المضادات الحيوية مع التركيز على العنقوديات الذهبية.
قراءات إضافية ومصادر للتوسع
- Archer, G. L. (1998). Staphylococcus aureus: A Well-Armed Pathogen. Clinical Infectious Diseases, 26(5), 1179–1181.
DOI: 10.1086/520289
لماذا نقترح عليك قراءته؟ ورقة كلاسيكية مختصرة لكنها تقدم رؤية استثنائية عن آليات الإمراض، وهي مدخل ممتاز للباحث المبتدئ قبل الغوص في المراجعات الأطول. - Otto, M. (2009). Staphylococcus epidermidis — the ‘accidental’ pathogen. Nature Reviews Microbiology, 7(8), 555–567.
DOI: 10.1038/nrmicro2182
لماذا نقترح عليك قراءته؟ هذه المراجعة هي المرجع الأول عالمياً لفهم المكورات العنقودية البشروية ودورها في عدوى الأجهزة الطبية، وتقدم شرحاً عميقاً لآلية تكوين الغشاء الحيوي. - DeLeo, F. R., & Chambers, H. F. (2009). Reemergence of antibiotic-resistant Staphylococcus aureus in the genomics era. Journal of Clinical Investigation, 119(9), 2464–2474.
DOI: 10.1172/JCI38226
لماذا نقترح عليك قراءته؟ يربط بين علم الجينوم والمقاومة الدوائية، ويشرح كيف ساعدت تقنيات التسلسل الجيني في فهم انتشار MRSA عالمياً — مفيد جداً لطلاب الدراسات العليا والباحثين في علم الأوبئة الجزيئية.
✅ مقال مُراجَع ومُدقَّق طبياً وعلمياً
تمت مراجعة هذا المقال وتدقيقه من قبل هيئة التحرير العلمية في موسوعة خلية وفقاً لسياسة التحقق والمراجعة العلمية المعتمدة.
آخر تحديث: يناير 2026 | khalieah.com




